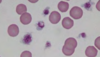

Blood & Hematopoiesis Flashcards
What sps has sickle-shaped erythrocyte?

deer
What sps has thrombocytes that are nucleated?

Avian, reptiles, amphibians
Electrophoresis: what is A?

Albumin
What do basophil granules contain?
When would basophils increase?
histamine; w parasitic infection & allergic rxn
What is lymphopoiesis?
Where are they derived from?
lymphocyte maturation:
pluripotent stem cell to lymphoid stem cell to B or T lymphocyte
What are the 2 types of bone marrow?
Red Marrow
Yellow Marrow
What are the 3 functions of whole blood?
transport, temperature regulation, water blanace & blood vol
What is electrophoresis used for?

to separate proteins by electrocal charge & size
What is the most numerous wbc in the body?
neutrophil
What is the second most numerous cell in the blood?
lymphocyte
What are the 3 types of small lymphocytes?
B cells & T cells
What are the 3 granuolocytes?
neutrophils
eosinophils
basophils
What sps has a smaller erythrocytes w small or no central pallor?

Feline
What is a leukocyte?
What does it counteract?
white blood cell involved w counteracting foreign substrates & disease?
What is the process where specialized cellular processes devel into hightly differentiated cells of peripheral blood?
Hematopoiesis
What sps has a nucleated erythrocyte?

birds, reptiles, amphibians, fish
What is stroma?
What is it composed of?
CT network composed of mesenchymal cells, reticular cells, reticular fibers
What sps has ovoid erythrocyte?

Camalid
What does red marrow produce and what does it store?
all blood cells & stores iron
What is albumin’s role?
electron transport & maintians colloid oncotic pressure to keep fluid within blood
C What type of leukocyte has a large, dense nucleus w pale cytoplsam?

lymphocyte
What are the formed elements composed of?
Erythrocytes
Leukocytes
Thrombocytes
What is a erythrocyte?
What does it contian/carry?
Red blood cell containing hemoglobin which carries oxygen from lungs to tissues & CO2 from tissues to lungs
What is Monopoiesis?
What are they derived from?
monocyte maturation:
myeloid stem cell to monoblast to promonocyte to monocyte